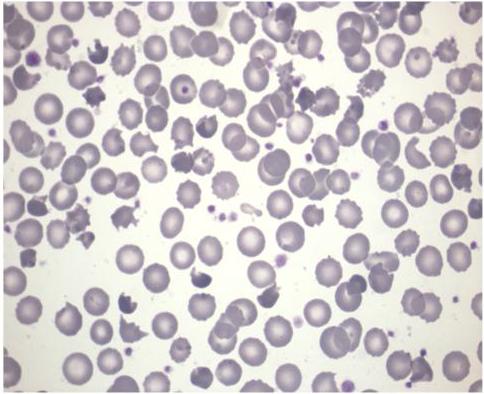

La picnocitosi infantile: una causa rara ma non infrequente di anemia emolitica neonatale severa
Unità Operativa Complessa di Pediatria - TIN, Ospedale “Umberto I”, Nocera Inferiore, Salerno
Indirizzo per la corrispondenza: aurinoanna@hotmail.com
Infantile pyknocytosis: a rare but not infrequent cause of severe neonatal haemolytic anaemia
Key words
Infantile pyknocytosis, Erythropoiesis, Flow cytometry, Erythropoietin
Abstract
The diagnosis and treatment of six patients with infantile pyknocytosis are reported. The clinical course and the diagnostic work-up are shown. All the patients necessitated therapy: phototherapy in five patients and one red blood cell transfusion in all of them; in two patients, because of the persistence of haemolysis and pyknocytosis with inadequate erythropoiesis, a brief course of erythropoietin treatment was undertaken with an excellent response and no side effects. Infantile pyknocytosis is a rare but not infrequent disease: physicians caring for a neonate with haemolytic anaemia should not forget this disease in the differential diagnosis.
Riassunto
Gli Autori riportano sei casi di picnocitosi infantile, diagnosticati e trattati nel loro reparto. Scopo del lavoro è descrivere il decorso clinico e la diagnosi. Tutti i pazienti hanno praticato terapia: fototerapia in cinque pazienti, trasfusione di emazie concentrate in tutti. In due pazienti si è reso necessario un breve e risolutivo trattamento con eritropoietina dal momento che vi era una persistenza dell’emolisi e della picnocitosi con una inadeguata eritropoiesi. La picnocitosi infantile è una rara ma non infrequente patologia che deve sempre essere considerata nella diagnostica differenziale delle anemie emolitiche del neonato.
Introduzione
Si definisce anemia una condizione caratterizzata dalla diminuzione del contenuto di emoglobina (Hb) e/o del valore dell’ematocrito al di sotto di due deviazioni standard dei valori normali per l’età e per il sesso1. L’equilibrio tra distruzione e produzione dei globuli rossi rappresenta la condizione fondamentale per un adeguato mantenimento del loro numero e della concentrazione dell’emoglobina del sangue periferico. Si determina anemia quando questo equilibrio viene modificato e ciò a causa, fondamentalmente, di tre meccanismi patogenetici quali :
- perdita di eritrociti (emorragia materno-fetale, malformazioni placentari, sottrazione iatrogena di sangue ecc.)
- ridotta produzione di eritrociti (infezioni congenite o acquisite, leucemie, anemia di Diamond- Blackfan ecc.)
- accentuata distruzione di eritrociti (o emolisi), che può essere dovuta a cause extracellulari (immunologiche, fattori plasmatici o meccanici ecc.) o intracellulari (alterazioni ereditarie della membrana del globulo rosso, difetti enzimatici eritrocitari, emoglobinopatie ecc.).
Come conseguenza dell’aumentata distruzione dei globuli rossi si ha:
1) aumentata immissione e presenza nel circolo sanguigno di reticolociti (o eritrociti giovani)
2) aumentati livelli sierici di bilirubina indiretta
3) ridotti livelli sierici di due proteine plasmatiche, l’aptoglobina e l’emopessina
Nel bambino questi dati laboratoristici vengono utilizzati comunemente per la diagnosi di un processo emolitico. Nel neonato invece l’interpretazione è più difficile perché la reticolocitosi non è così spiccata, per una risposta eritropoietica midollare più “pigra”; l’iperbilirubinemia è presente già fisiologicamente e i livelli sierici di aptoglobina e emopessina sono fisiologicamente bassi nei primi tre mesi di vita.
SCOPO del nostro lavoro è quello di ricordare al neonatologo/pediatra che, tra le cause di anemia emolitica dei primi mesi di vita, non bisogna dimenticare la picnocitosi infantile. Questa malattia fu descritta per la prima volta da Tuffy et al.2, ed è caratterizzata da un’anemia emolitica transitoria dei primi mesi di vita associata a un’aumentata presenza, all’osservazione dello striscio periferico, di eritrociti con diametro ridotto, colorazione intensa e alterazioni strutturali di membrana (proiezioni simili a processi spinosi) e da loro denominati “picnociti”: nei neonati a termine normali il numero dei picnociti all’osservazione dello striscio periferico nei primi giorni di vita non supera il 3%, riducendosi fin quasi a scomparire al terzo mese di vita; una percentuale leggermente superiore, fino al 5%, si può osservare nei neonati pretermine, ma solo nei primi giorni di vita2 Questi eritrociti abnormi sono del tutto sovrapponibili agli “acantociti”, ovverosia globuli rossi morfologicamente alterati, riscontrabili in numerose condizioni morbose sia congenite che acquisite, quali l’abetalipoproteinemia, danni epatici severi ecc.3-4. Gli Autori presentano pertanto la loro casistica.
CASISTICA
In un periodo compreso tra il 2005-2009, gli Autori hanno posto diagnosi di picnocitosi infantile in sei neonati (tre di sesso maschile e tre di sesso femminile) giunti alla loro osservazione per pallore cutaneo, ittero accentuato e anemia emolitica (Tabella I). L’anamnesi familiare era negativa per malattie ematologiche: non vi era consanguineità tra genitori, il cui fenotipo ematologico era del tutto normale; in particolare non veniva segnalata ittero e anemia neonatale nei genitori o in altri fratelli dei pazienti. Era esclusa una incompatibilità materno- fetale (il test di Coombs era negativo in tutti i pazienti). Tutti i pazienti erano nati da gravidanza normocondotta, a termine, con peso appropriato all’età gestazionale e normale evoluzione dei fenomeni perinatali; 4 pazienti erano nati da parto cesareo.
Nell’anamnesi patologica remota era da segnalare insorgenza di ittero precoce, entro la terza giornata di vita, in due pazienti, con valori medi di bilirubinemia totale (BT) di 17,3 mg/dl (range 17,1-17,8 mg/dl), e tardivo, tra l’ottavo e il quindicesimo giorno di vita, negli altri BT 19,05 mg/dl (range 16,5-20,0mg/dl). Tutti sono stati ricoverati; all’ingresso l’esame clinico mostrava pallore cutaneo e colorazione giallastra della cute e delle sclere; non era riscontrata epato-splenomegalia. Cinque pazienti hanno praticato almeno un ciclo di fototerapia, con progressiva normalizzazione della iperbilirubinemia in tutti. In un paziente l’iperbilirubinemia si è ripresentata in decima e tredicesima giornata, richiedendo altri due cicli di fototerapia. L’analisi del DNA ha evidenziato che il neonato era omozigote per una variante del promoter del gene responsabile della sintesi dell’enzima uridin-difosfato-glicuroniltransferasi o UGT1A1, variante che determina una ridotta trascrizione del gene con conseguente riduzione dell’attività enzimatica e costituisce la base molecolare della sindrome di Gilbert5. Tra il dodicesimo e il quindicesimo giorno di vita si è verificata in tutti i pazienti una progressiva anemizzazione fino a valori di Hb compresi tra 6-7,2 mg/dl. In tutti i pazienti risultavano normali la funzionalità epato-renale, il quadro lipoproteico, le indagini virologiche, le resistenze osmotiche, gli enzimi eritrocitari (glucosio-6-fosfoto-deidrogenasi o G6PD e piruvato-chinasi), l’elettroforesi dell’emoglobina e lo studio delle proteine di membrana del globulo rosso. Diagnostico era invece lo striscio di sangue periferico che mostrava, in tutti i pazienti, un aumentata presenza (35-40%) di picnociti (Figura 1). Lo studio mediante citometria a flusso degli eritrociti e dei reticolociti dei pazienti mostrava un aspetto del tutto peculiare e caratteristico6-7: aumentata percentuale di emazie iperdense, cioè con una concentrazione di Hb > 41g/dl (10-13,5%, V.N. < 3%), una abnorme asimmetria della curva di distribuzione della concentrazione dell’Hb eritrocitaria e una normale simmetria della curva di distribuzione dell’Hb reticolocitaria (Figura 2). È stata praticata in tutti terapia trasfusionale con emazie concentrate: in 4 pazienti si è osservata riduzione prima e scomparsa successiva, in un periodo compreso tra i 2 e 3 mesi, della percentuale di picnociti allo striscio periferico; tutti stanno bene a un follow-up minimo di 12 mesi. In due pazienti, dopo la trasfusione, non si verificò un miglioramento dell’emolisi e della picnocitosi, ma una progressiva riduzione dei livelli dell’Hb (6,5-6,8 mg/dl, rispettivamente) con una reticolocitosi non adeguata (90,0 x 109/l e 108,0 x 109/l rispettivamente). Per tale motivo, supportati anche dai valori normali dell’eritropoietina sierica (9 e 18 UI/l, rispettivamente, V.N.= 4-25 UI/l), dopo consenso informato dei genitori, fu iniziata terapia con eritropoietina ricombinante (rHu-Epo) alla dose di 1000 UI/kg/settimana associata a supplementazione marziale, così come segnalato in letteratura per neonati affetti da sferocitosi ereditaria severa8. In entrambi i pazienti si ebbe una progressiva ripresa dei valori dell’Hb e un incremento della conta reticolocitaria fino alla completa normalizzazione dopo quattro e sei settimane, rispettivamente; la terapia con rHu-Epo fu poi ridotta e sospesa in tre settimane; entrambi i pazienti stanno bene a un follow-up di 12 e 18 mesi rispettivamente. Non vi furono effetti collaterali della terapia. Tutti i sei pazienti hanno presentato un normale accrescimento staturo-ponderale e un normale sviluppo psicomotorio.
Discussione
La picnocitosi infantile fu descritta per la prima volta nel 1959 da Tuffy et al.2, i quali studiarono 11 neonati affetti da tale patologia Dopo questa prima descrizione vi sono state in letteratura solo poche altre segnalazioni di tale affezione morbosa9-12 fino al lavoro del gruppo di ematologi pediatrici francesi dell’Ospedale di Bicetre6 , che in studio retrospettivo su 149 casi anemia neonatale inspiegata inviati alla loro osservazione dal 2002 al 2004, individuarono 14 casi (10% circa della loro casistica) di picnocitosi infantile e la successiva casistica di 5 casi descritta da un gruppo di ematologi pediatrici belgi13: pertanto la picnocitosi è una malattia rara ma non infrequente. L’eziologia di questa patologia è ancora sconosciuta. Si ritiene che le alterazioni morfologiche eritrocitarie sopra descritte non siano intrinseche all’eritrocita stesso e ciò è supportato da due evidenze: la transitorietà del processo emolitico e la rapida trasformazione in picnociti delle emazie trasfuse nei soggetti ammalati4. Inoltre l’alterazione interessa solo gli eritrociti e non i reticolociti, come confermato dallo studio citometrico delle popolazioni eritrocitarie e reticolocitarie6-7. L’ipotesi patogenetica potrebbe pertanto essere ricondotta alla possibile presenza di un fattore transitorio extracellulare, di natura sconosciuta, che interagendo con la membrana eritrocitaria ne determinerebbe le modificazioni descritte e la precoce distruzione. Nella maggioranza dei casi la diagnosi è abbastanza agevole, tenendo conto della mancanza di ereditarietà (sporadica è la descrizione di forme familiari11-14, del decorso clinico (anemia emolitca severa a insorgenza tardiva, in genere dopo la seconda settimana di vita), dell’osservazione attenta dello striscio periferico con le caratteristiche alterazioni morfologiche delle emazie, dello studio mediante citometria a flusso degli indici eritrocitari e reticolocitari6-15, insieme con l’effettuazione di pochi altri esami (test di Coombs, studio della funzionalità epatica e delle lipoproteine sieriche); solo nei casi dubbi saranno necessari ulteriori indagini (elettoforesi dell’emoglobina, dosaggio degli enzimi eritrocitari, dosaggio della vitamina E, studio delle proteine della membrana eritrocitaria ecc.), tenendo conto delle altre cause di anemia emolitica neonatale (Tabella II16): ciò è estremamente importante trattandosi di neonati e per di più anemici. In conclusione, la picnocitosi infantile è una affezione morbosa grave, che richiede quasi sempre terapia: fototerapia, trasfusioni di emazie concentrate e/o exanguino-trasfusioni, e va sempre tenuta presente, nella diagnostica differenziale, quando ci si confronta con un neonato affetto da ittero tardivo e successiva progressiva anemizzazione. Interessante è il rapido miglioramento dell’anemia e la drastica riduzione della percentuale dei picnociti allo striscio periferico, che si è osservato con l’utilizzo di rHu-Epo in pazienti che presentavano valori “normali” di eritropoietina e nei quali non si era verificato un miglioramento dell’emolisi e della picnocitosi dopo emotrasfusione. Tale terapia ha rapidamente normalizzato il quadro ematologico, dimostrandosi efficace nel prevenire ulteriori trasfusioni di emazie concentrate7.
Tabella I. Dati clinici ed ematologici dei pazienti affetti da picnocitosi
Legenda: M = sesso maschile; F = sesso femminile; TC = taglio cesareo; Tx = trasfusione di emazie concentrate
*Valori prima della Tx
Tabella II. Cause di anemia emolitica neonatale
Immunitari: Incompatibilità Rh, Incompatibilità ABO, Incompatibilità da gruppi minori, Anemia emolitica autoimmune materna, Anemia emolitica da farmaci
Infettive: Sepsi, Infezioni congenite
Vascolari: Coagulazione intravasale disseminata, Anemia macroangiopatica e microangiopatica, Emangioma o emangioendotelioma cavernoso, Stenosi dell’arteria renale, Coartazione aortica severa
Difetti della membrana eritrocitaria: Sferocitosi, Ellissocitosi, Stomatocitosi, Xerocitosi, Picnocitosi
Difetti enzimatici eritrocitari: Deficit di glucosio 6 fosfato deidrogenasi, Deficit di piruvato chinasi, Deficit 5’ nucleotidasi, Deficit di glucosio fosfato isomerasi
Difetti qualitativi e quantitativi della produzione dell’emoglobina: α Thalassemia, Anomalie strutturali delle catene α; γ Thalassemia, anomalie strutturali delle catene γ
Difetto di vitamina E
Galattosemia
Prolungata o ricorrente acidosi metabolica o respiratoria
Figura 1. Striscio periferico di neonato affetto da picnocitosi ereditaria: presenza di numerosi eritrociti abnormi, ipercromici con proiezioni spinose.
Figura 2. Valutazione mediante citometria a flusso del volume cellulare eritrocitario e della concentrazione emoglobinica dei globuli rossi e dei reticolociti di un neonato affetto da picnocitosi infantile.

Bibliografia
Brugnara C. Reference values in infancy and childhood. In: Orkin SH, Nathan DG, Ginsburg D, Look AT, Fisher DE, Lux SE (EDS). Nathan and Oskìs Hematology of Infancy and Childhood. Philadelphia: Saunders Elsevier Inc 2009;1769-96.
Tuffy P, Brown AK, Zuelzer WW. Infantile Pyknocytosis: a common erythrocyte abnormality of the first trimester. A J Dis Child 1959;98:103-07.
Biemer JJ. Acanthocytosis: biochemical and physiological considerations. Ann Clin Lab Sc 1980;10:238-49.
Grace RF, Lux SE. Disorders of the red cell membrane. In: Orkin SH, Nathan DG, Ginsburg D, Look AT, Fisher DE, Lux SE (EDS). Nathan and Oskìs Hematology of Infancy and Childhood. Philadelphia: Saunders Elsevier Inc 2009;659-837.
Miraglia del Giudice E, Perrotta S, Nobili B, Specchia C, d’Urzo G. Coinheritance of Gilbert syndrome increases the risk of developing gallstones in patients with hereditary spherocytosis. Blood 1999;7:2259-62.
Eyssette-Guerreau S, Bader-Meunier B, Garcon L, Guitton C, Cynober T. Infantile pyknocytosis: a cause of haemolytic anemia of the newborn. British J Haematol 2006;133:439-42.
Amendola G, Di Concilio R, d’Urzo G, et al. Erythropoietin treatment can prevent blood transfusion in infantile pyknocytosis. British J Haematol 2008;143: 593-95.
Tchernia G, Delhommeau F, Perrotta S, et al. Recombinant erythropoietin therapy as an alternative to blood transfusions in infants with hereditary spherocytosis. The Hematology Journal 2000;1:146-52.
Keimonwitz R, Desforges J F. Infantile pyknocytosis. N Engl J Med 1965;273:1152-55.
Ackerman B D. Infantile pycnocytosis in Mexican-American infant. A J Dis Child 1969;117:417-23.
Maxwell Seshadri R, Rumpf DJ, Miller JM. Infantile pyknocytosis a cause of intrauterine haemolysis in two siblings. New Zeeland J Obstet Gynaecol 1983; 23:182-85.
Dabbous I A, El Bahlawan L. Infantile pyknocytosis: a forgotten or a dead diagnosis? J Pediatr Hemathol Oncol 2002;24:507.
Limme B, Dresse MF, Ketlslegers O, Rigo V, Hoyoux C. Infantile pyknocytosis: a rare form of neonatal hemolytic anemia. 5 case-studies. Arch Pediatr 2008;15:1765-68.
Dahoui HA, Abboud MR, Saab R, et al. Familial infantile pyknocytosis in association with pulmonary hypertension. Pediatr Blood Cancer 2008;51:290-92.
Amendola G, Di Concilio R, d’Urzo G, et al. Valutazione citometrica degli eritrociti e dei reticolociti nella diagnosi delle anemie emolitiche neonatali. Haematologica 2007;92 (Suppl 1):63.
Brugnara C, Platt OS. The neonatal erythrocyte and its disorders. In: Orkin SH, Nathan DG, Ginsburg D, Look AT, Fisher DE, Lux SE (EDS). Nathan and Oskìs Hematology of Infancy and Childhood. Philadelphia: Saunders Elsevier Inc 2009;21-66.
